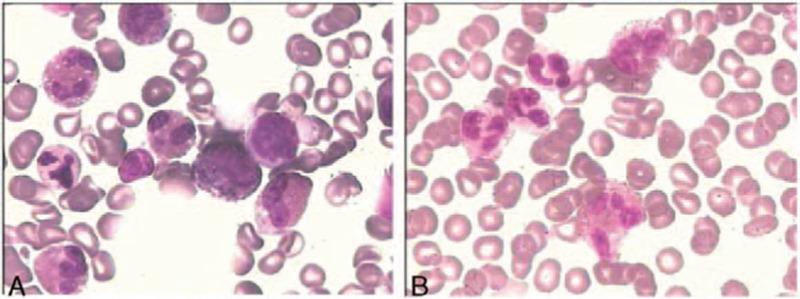

以多器官浸润和深静脉血栓形成表现的高嗜酸性粒细胞综合征:一例报告及文献复习
Hypereosinophilic syndrome presenting with multiple organ infiltration and deep venous thrombosis: A case report and literature review.
作者信息
Gao Su-Jun, Wei Wei, Chen Jiang-Tao, Tan Ye-Hui, Yu Cheng-Bao, Litzow Mark Robert, Liu Qiu-Ju
机构信息
Hematology section, Cancer Center, the First Hospital of Jilin University Department of Urology, The First Hospital of Jilin University, Changchun, Jilin, China Division of Hematology, Mayo Clinic, Rochester, Minnesota, USA Second Department of Cardiology, The First Hospital of Qiqihaer Hospital, Qiqihaer, Heilongjiang, China.
出版信息
Medicine (Baltimore). 2016 Aug;95(35):e4658. doi: 10.1097/MD.0000000000004658.
BACKGROUND
Hypereosinophilic syndrome (HES) can be fatal, particularly when eosinophils infiltrate vital organs and/or if extensive thrombosis develops. However there are no standard recommendations for the use of anticoagulant therapy of HES in the setting of thrombosis.
METHODS
We herein present a case of a 46-year-old female who presented with marked peripheral eosinophilia with symptoms of multi-organ infiltration and extensive deep venous thrombosis (DVT). In this case, evaluation was carried out before the diagnosis was established, and timely standard-dose corticosteroids combined with a new oral anticoagulant (NOAC) therapy were carried out.
RESULTS
These measures resulted in a rapid response and long-term disease control.
CONCLUSION
Although there are no data to support which anticoagulant is preferred in this setting, this case indicates that the new oral anticoagulants may play an important role in the treatment of thrombosis in HES.
背景
高嗜酸性粒细胞综合征(HES)可能是致命的,特别是当嗜酸性粒细胞浸润重要器官和/或发生广泛血栓形成时。然而,对于HES合并血栓形成时使用抗凝治疗,尚无标准建议。
方法
我们在此报告一例46岁女性患者,其外周血嗜酸性粒细胞显著增多,伴有多器官浸润症状和广泛的深静脉血栓形成(DVT)。在本病例中,在确诊前进行了评估,并及时给予标准剂量的皮质类固醇联合新型口服抗凝剂(NOAC)治疗。
结果
这些措施带来了快速反应和疾病的长期控制。
结论
虽然尚无数据支持在这种情况下哪种抗凝剂更优,但该病例表明新型口服抗凝剂可能在HES血栓形成的治疗中发挥重要作用。